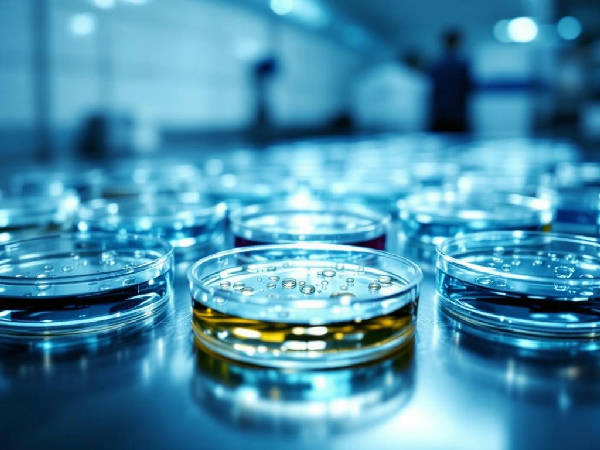
Chan Zuckerberg Biohub: 500 Millionen Dollar für KI-gestützte Zellbiologie

YouTube bringt PiP nun global. Die Funktion war auf mobilen Geräten lange nur zahlenden Premium-Nutzern vorbehalten oder technisch umständlich über Browser-Workarounds erreichbar. Jetzt ändert sich das: Das schwebende Minifenster bleibt aktiv, während Nutzer andere Apps öffnen, scrollen oder tippen. Streaming-Konkurrenten wie Netflix, Disney+ und das Apple-TV-Ökosystem haben diesen Standard schon länger gesetzt – YouTube holt damit eine Lücke auf, die im Alltag täglich spürbar war.
- YouTube schaltet die Bild-in-Bild-Funktion (PiP) auf Smartphones jetzt weltweit auch ohne Premium-Abo für Nicht-Musik-Inhalte frei.
- Content-Creator können sich auf höhere Wiedergabezeiten freuen, da Videos beim Multitasking der Nutzer einfach im Hintergrund weiterlaufen.
- Mit diesem Update positioniert sich YouTube strategisch als allgegenwärtige Medienebene, die den Medienkonsum ohne Reibungsverluste maximiert.
Für Content-Ersteller ist das direkt relevant: Videos, die im Hintergrund weiterlaufen, erhöhen potenziell die Gesamtwatchtime. Algorithmen werten Wiedergabezeit als zentrales Ranking-Signal – PiP könnte diesen Wert auch dann steigern, wenn die Aufmerksamkeit des Nutzers längst woanders ist.
Die Timing-Entscheidung passt in ein größeres Bild. YouTube baut laut aktueller Berichterstattung von TechCrunch aggressive interaktive Features für vernetzte Fernseher aus: Sprachsuche, Second-Screen-Companion-Funktionen und immersivere Live-Erlebnisse sollen die Plattform tiefer ins Wohnzimmer bringen. Parallel dazu integriert YouTube mehr KI-gestützte Tools wie Vision Language Models in Suche, Empfehlungen und Creator-Workflows. PiP auf dem Smartphone fügt sich exakt in diese Strategie ein: YouTube soll auf jedem Bildschirm, zu jeder Zeit, in jedem Nutzungskontext verfügbar sein.
Das ist eine andere Positionierung als bisher. Statt einer Ziel-App, die volle Aufmerksamkeit einfordert, positioniert sich YouTube zunehmend als persistente Medienebene – immer präsent, auch wenn der Fokus wechselt. Wer Medienzeit gewinnen will, muss Reibung minimieren. PiP minimiert genau diese Reibung.
Der globale PiP-Rollout ist kein isoliertes Feature-Update, sondern ein Signal: YouTube investiert systematisch in Nutzbarkeit über App-Grenzen hinweg. Die nächsten logischen Schritte – persistente Audiowiedergabe ohne Premium, tiefere Betriebssystem-Integration, erweiterte Second-Screen-Synchronisation mit dem TV – liegen auf der Hand. Im Kampf um Bildschirmzeit sind es oft nicht die auffälligen neuen Produkte, die den Unterschied machen. Manchmal reicht es, einfach nicht mehr zu stoppen, wenn jemand die App verlässt. Das setzt Druck auf Plattformen, die ähnliche Nutzererwartungen noch nicht erfüllen.
❓ Häufig gestellte Fragen
✅ 8 Claims geprüft, davon 3 mehrfach verifiziert
📚 Quellen